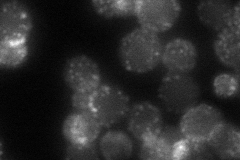
YBL047C
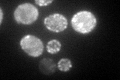
YBL047C

View description
Key endocytic protein involved in a network of interactions with other endocytic proteins, binds membranes in a ubiquitin-dependent manner, may also bind ubiquitinated membrane-associated proteins
Localization:
Intensity:
Fold change:
Significance:
-
C’ GFP library in SD

cell periphery, bud neck -
N' NOP1pr-GFP in SD

punctate,bud neck174.11 -
N' TEF2pr-mCherry in SD

punctate150.133 -
N' NATIVEpr-GFP in SD
punctate,bud neck59.0879 -
N' TEF2pr-VC and Cyto-VN in SD

punctate46.6111 -
C’ GFP library in SD+DTT

punctateN/AN/ANo -
C’ GFP library in SD+H2O2

punctateN/AN/ANo -
C’ GFP library in Starvation Media
punctateN/AN/AYes -
C’ GFP library on the background of Pup2-DaMP

cell periphery, bud neck -
C’ GFP library on the background of CCT mutant

cell periphery, bud neck122.6361.14866No
